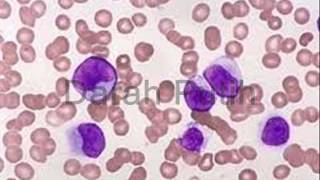

- Interpretasi Citra Penginderaan Jauh

Video pembelajaran ini dibuat untuk Anda yang memerlukannya. Watch Now
Watch Now
- 2.3 Interpretasi Citra - Geografi

Semoga adik-adik masuk PTN yang diinginkan :) Channel ini dibuat untuk mengedukasi calon mahasiswa supaya memudahkan masuk PTN yang di inginkan ... Watch Now
Watch Now
- Problem Base Learning : Unsur-unsur intepretasi hasil citra foto udara

Jam ke 7 dan 8, pkl. 12.30 - 14.00 WIB. ABAIKAN Tikar sajadah tempat para siswi Shalat Dhuhur. Watch Now
Watch Now
- BELAJAR INTERPRETASI CITRA SATELIT

VIDEO PENJELASAN SINGAKT BELAJAR INTERPRETASI CITRA SATELIT. Watch Now
Watch Now
- CITRA FOTO PENGINDERAAN JAUH

Video Pembelajaran Mengenai Jenis Citra pada Penginderaan Jauh Mencakup Materi Tentang Citra Foto. Watch Now
Watch Now
- Tutorial Pengumpulan Data dan Interpretasi Citra Satelit Landsat 8 Part II

Tutorial ini merupakan sarana untuk panduan dalam melakukan interpretasi citra satelit landsat 8 menggunakan metode image classifiation. Software yang ... Watch Now
Watch Now
- INTERPRETASI PETA

 Watch Now
Watch Now
- Video Pembelajaran Geografi Interpretasi Citra Media Google Earth

Pembelajaran Mata Pelajaran Geografi pada Materi Interpretasi Citra Penginderaan Jauh Menggunakan Media Google Earth di SMA Negeri 1 Metro Provinsi ... Watch Now
Watch Now
- INTERPRETASI CITRA DIGITAL tentang RESOLUSI

Nama : Yopi yunita Nim : 1101556 Jurusan: Geografi presentasi Interpretasi Digital tentang Resolusi. Watch Now
Watch Now
- UAV Foto Udara #nightvision

 Watch Now
Watch Now
- CITRA PENGINDERAAN JAUH

Created using PowToon -- Free sign up at http://www.powtoon.com/youtube/ -- Create animated videos and animated presentations for free. PowToon is a free ... Watch Now
Watch Now
- Aerial Monitoring - Citra Angkasa Geosmart

PT Citra Angkasa Geosmart merupakan penyedia jasa layanan Aerial Mapping, Aerial Photography, Aerial Video dan Pengadaan UAV Systems yang dibangun ... Watch Now
Watch Now
- Cara Download Citra Landsat 8 Komposit Warna dan Penajaman Citra

Cara Download Citra Landsat 8 disini https://libra.developmentseed.org/ Pengolahan Komposit Warna True Color Band 4,3,2 Penajaman Citra Satelit Landsat ... Watch Now
Watch Now
- Mendownload Citra Resolusi Tinggi pada Ina Geoportal

Syarat penggunaan data ini adalah dengan adanya koneksi internet. Music by: Black Number - Shiawase. Watch Now
Watch Now
- media pembelajaran citra
Watch Now
Watch Now
Monday, September 23, 2019
Unsur Unsur Interpretasi Foto Udara
Subscribe to:
Post Comments (Atom)
No comments:
Post a Comment